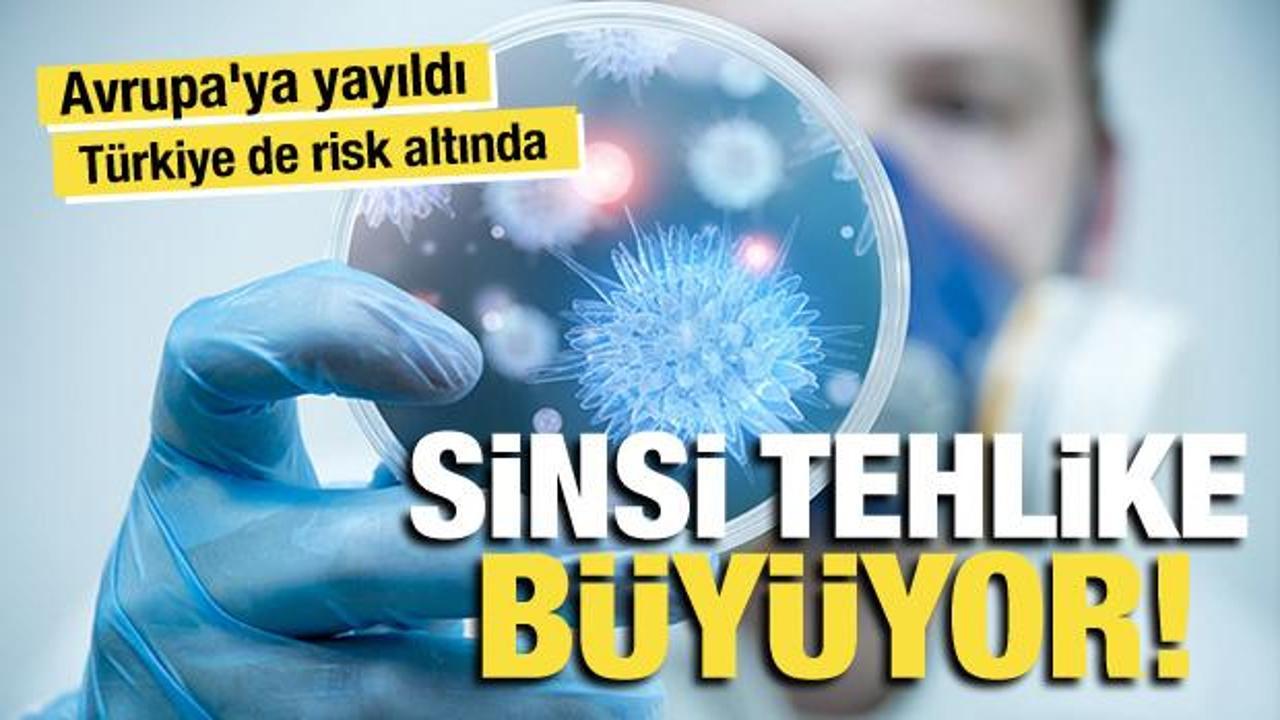
DSÖ’den Chikungunya uyarısı: 5,6 milyar kişi risk altında! Türkiye’de de görüldü

Bugun...
ÇOK OKUNAN HABERLER
- BUGÜN
- BU HAFTA
- BU AY
SON YORUMLANANLAR
- HABERLER
- VİDEOLAR
HABER ARŞİVİ
HAVA DURUMU
PUAN DURUMU
| Takım | O | G | M | B | A | Y | P | AV |
|---|
| Takım | O | G | M | B | A | Y | P | AV |
|---|
| Takım | O | G | M | B | A | Y | P | AV |
|---|
| Takım | O | G | M | B | A | Y | P | AV |
|---|
| Tarih | Ev Sahibi | Sonuç | Konuk Takım |
|---|
| Tarih | Ev Sahibi | Sonuç | Konuk Takım |
|---|
| Tarih | Ev Sahibi | Sonuç | Konuk Takım |
|---|
| Tarih | Ev Sahibi | Sonuç | Konuk Takım |
|---|

GAZETEMİZ

ANKET
Henüz anket oluşturulmamış.
NAMAZ VAKİTLERİ
GÜNLÜK BURÇ




HABER ARA